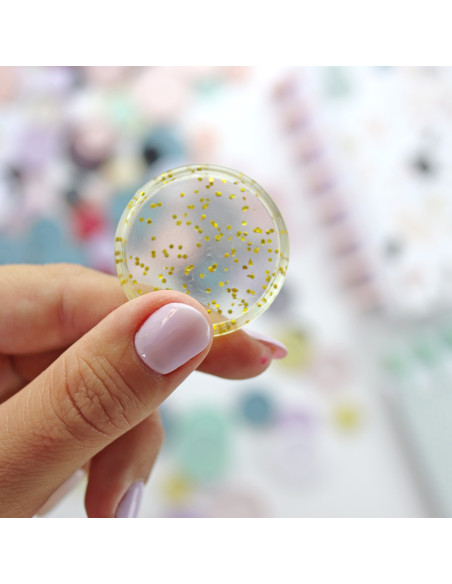
Disco MEDIANO para encuadernar

Disco MEDIANO para encuadernar
Este disco para encuadernar Mediano es un elemento imprescindible para las encuadernaciones de disco de formato pequeño o las que llevan pocas páginas.
Características principales:
- Tamaño: 35 mm
- Material: plástico
Este disco para encuadernar Mediano es un elemento imprescindible para las encuadernaciones de disco de formato pequeño o las que llevan pocas páginas.
Tiene un diámetro de 35 mm y está realizado en plástico muy resistente, por el que se deslizan las hojas con facilidad.
Tienes este mismo tamaño de discos en diferentes colores: rosa bailarina, verde menta, nude, purpurina, gris topo, blanco, negro, amarillo, denim, cereza, lila y princesa purpurina.
Para facilitar este tipo de encuadernación tan versátil, además disponemos de guías de disco para crear portadas y separadores de disco para utilizar entre las páginas del proyecto. Lo tienes todo aquí.
Recuerda que, para realizar encuadernaciones de disco, es imprescindible una perforadora para planners de disco, como la Crop a Dile Disc Power Punch, de We R Memory Keepers.
Características principales:
- Tamaño: 35 mm
- Material: plástico
Producto importado
Empaquetado en Galicia con amor.